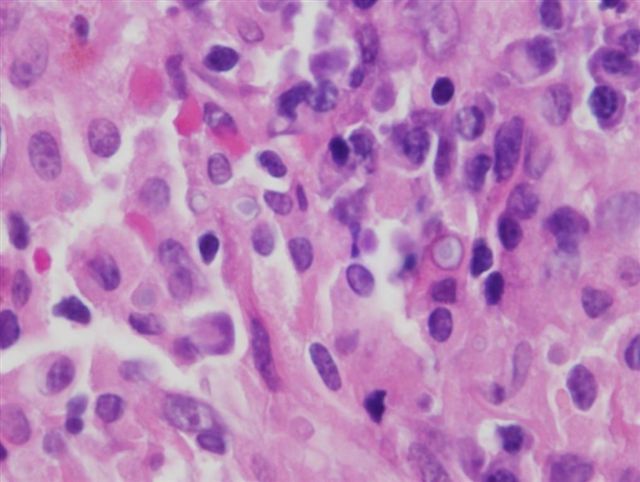

Possible complication of the finding in this bladder U/S?

Infection due to urinary stasis
(Evagination of bladder wall = diverticulum)
What caused this finding on cystoscopy?

Chronic inflammation of the ureter
(Cysts in the ureter = urethritis cystica)
A 50 yo male non-smoker who recently moved from Cairo presents with hematuria and weight loss. Most likely diagnosis?
Squamous cell carcinoma of bladder associated with schistosoma haematobium
(Classic presentation according to Handorf; the oval things are the schistosoma??)

List a congenital cause of bladder diverticulum.
Patency of the bladder end of urachus

A 15 yo male presents to your office with his 8th UTI since childhood. A possible explanation may be:
Vesicoureteral reflux due to a congenital malformation of the vesicoureteral junction (ex. 90 degree angle)
(Notice the dilation is proximal to the vesicoureteral junction)

What would this lesion look like histologically?

Highly vascularized, heavily infiltrated with leukocytes, fibroblastic connective tissue
A 60 yo male with a 40 pack year history presents with a 3 month history of hematuria and weight loss. Most likely diagnosis?
Urothelial carcinoma
(Highly associated with smoking and most common presentation is hematuria)

Also check for?
Possible complication?
Treatment?

Epispadias
Adenocarcinoma
Neobladder built from small bowel
(Bladder exstrophy)
Most common cause?

Bacterial infection (NOT chemo!!)
(Hemorrhagic cystitis)
What causes this finding? In whom is it more common?

Abnormal organization of &/or excess deposition of collagen between smooth muscle bundles
Boys, especially on left side
(Dilation of pelvis but not ureter = ureteropelvic junction obstruction)
A patient presents with vaginal discharge and sterile pyuria on UA. You also notice the finding below. What else should you ask about?

Arthralgia
(Urethritis + conjunctivitis + arthritis = Reiter syndrome due to chlamydia)
What condition is illustrated here?

Cystocele
(Protrusion of bladder into vagina)
A 45 yo woman presents with dysuria, intermittent hematuria, and suprapubic pain. Her UA and STD cultures show no evidence of infection. Cystoscopy reveals the below finding. Dx?

Interstitial cystitis (Hunner ulcer)
(This is thought to be autoimmune, so is more common in middle-aged women and presents with the listed symptoms in ABSENCE OF BACTERIAL INFECTION)
A patient who works in antique furniture restoration presents with hematuria and weight loss. Most likely diagnosis?
Urothelial carcinoma
(Aniline dye!! Used to dye furniture?)
A urethral biopsy from a patient with longstanding urinary retention reveals this finding. Dx?

Urethritis follicularis
(Chronic inflammation of ureter - think urethritis cystica or urethritis follicularis; if you see subepithelial lymphocytes = urethritis follicularis)
What was the cause of this finding on autopsy? What is its classical histological marker?

Abnormal immune response/histiocyte dysfunction to bacterial infection
Michaelis-Gutmann bodies (concretions between macrophages)
(Soft yellow plaques on bladder = malakoplakia)
This finding is pathognomonic for:

Sarcoma botyroides/embryonal rhabdomyosarcoma
(Grape-like projection from vagina!!)
20-40% of bladder adenocarcinoma is caused by:
Urachal cysts
(Patency of the central portion of the urachus)

This biopsy suggests a diagnosis of ___, putting this patient at an increased risk of ____.

Cystitis glandularis/cystica
Adenocarcinoma of bladder
(Look for clear spaces lined by cuboidal or urothelial epithelium)
List three risk factors for developing this lesion.

Cystitis glandularis
Urachal remnant
Exstrophy
(Adenocarcinoma - look for pleiomorphic cells lining glands)


